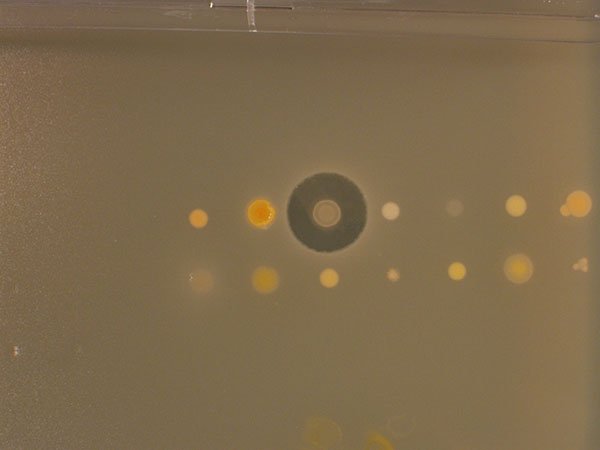

ಟ್ವೀಟ್ಗಳು
- ಟ್ವೀಟ್ಗಳು, ಪ್ರಸ್ತುತ ಪುಟ.
- ಟ್ವೀಟ್ಗಳು & ಪ್ರತಿಕ್ರಿಯೆಗಳು
- ಮಾಧ್ಯಮ
ನೀವು @NottinghamVets ಅವರನ್ನು ತಡೆಹಿಡಿದಿರುವಿರಿ
ಈ ಟ್ವೀಟ್ಗಳನ್ನು ವೀಕ್ಷಿಸಲು ನೀವು ಖಚಿತವಾಗಿ ಬಯಸುವಿರಾ? ಟ್ವೀಟ್ ವೀಕ್ಷಣೆಯು @NottinghamVets ಅವರ ತಡೆತೆರವುಗೊಳಿಸುವುದಿಲ್ಲ
-
NottinghamVetSchool ಅವರು ಮರುಟ್ವೀಟಿಸಿದ್ದಾರೆ
Students reveal
#superbug fighting microbes at#AMR Awareness Day http://ow.ly/vxmx30gDVRw@NottinghamVets@UoNBiosciencespic.twitter.com/FCie6c9IYN
ಧನ್ಯವಾದಗಳು. Twitter ಇದನ್ನು ನಿಮ್ಮ ಕಾಲರೇಖೆಯನ್ನು ಉತ್ತಮಗೊಳಿಸಲು ಬಳಸುತ್ತದೆ. ರದ್ದುಗೊಳಿಸು
ಧನ್ಯವಾದಗಳು. Twitter ಇದನ್ನು ನಿಮ್ಮ ಕಾಲರೇಖೆಯನ್ನು ಉತ್ತಮಗೊಳಿಸಲು ಬಳಸುತ್ತದೆ. ರದ್ದುಗೊಳಿಸು -
It has been great to host our new Vice-Chancellor Prof Shearer West
@NottinghamVets today!@shearerwest@UniofNottinghampic.twitter.com/tgf3axf6t8
 ಧನ್ಯವಾದಗಳು. Twitter ಇದನ್ನು ನಿಮ್ಮ ಕಾಲರೇಖೆಯನ್ನು ಉತ್ತಮಗೊಳಿಸಲು ಬಳಸುತ್ತದೆ. ರದ್ದುಗೊಳಿಸು
ಧನ್ಯವಾದಗಳು. Twitter ಇದನ್ನು ನಿಮ್ಮ ಕಾಲರೇಖೆಯನ್ನು ಉತ್ತಮಗೊಳಿಸಲು ಬಳಸುತ್ತದೆ. ರದ್ದುಗೊಳಿಸು -
NottinghamVetSchool ಅವರು ಮರುಟ್ವೀಟಿಸಿದ್ದಾರೆ
Are you on our Sutton Bonington campus tomorrow? Don't forget to check out some of the brilliant activities planned to mark
#Antibiotic Awareness Weekhttps://twitter.com/NottinghamVets/status/929987258098253824 …ಧನ್ಯವಾದಗಳು. Twitter ಇದನ್ನು ನಿಮ್ಮ ಕಾಲರೇಖೆಯನ್ನು ಉತ್ತಮಗೊಳಿಸಲು ಬಳಸುತ್ತದೆ. ರದ್ದುಗೊಳಿಸು -
NottinghamVetSchool ಅವರು ಮರುಟ್ವೀಟಿಸಿದ್ದಾರೆ
Hear our CEO
@Spr1969 - Sharon Redrobe OBE - in the new@TWBBC Electric Sheep podcast http://bbc.in/2hWil0T#MyTomorrowpic.twitter.com/Zxpo6qqcS2 ಧನ್ಯವಾದಗಳು. Twitter ಇದನ್ನು ನಿಮ್ಮ ಕಾಲರೇಖೆಯನ್ನು ಉತ್ತಮಗೊಳಿಸಲು ಬಳಸುತ್ತದೆ. ರದ್ದುಗೊಳಿಸು
ಧನ್ಯವಾದಗಳು. Twitter ಇದನ್ನು ನಿಮ್ಮ ಕಾಲರೇಖೆಯನ್ನು ಉತ್ತಮಗೊಳಿಸಲು ಬಳಸುತ್ತದೆ. ರದ್ದುಗೊಳಿಸು -
Antibiotic Awareness Day @VetMicroResearch this Wednesday in the Barn, 10am - 4pm. Come and share your thoughts, ideas and experiences of antimicrobial resistance and learn about what you can do to take action!
#freepizza#cakeಧನ್ಯವಾದಗಳು. Twitter ಇದನ್ನು ನಿಮ್ಮ ಕಾಲರೇಖೆಯನ್ನು ಉತ್ತಮಗೊಳಿಸಲು ಬಳಸುತ್ತದೆ. ರದ್ದುಗೊಳಿಸು -
NottinghamVetSchool ಅವರು ಮರುಟ್ವೀಟಿಸಿದ್ದಾರೆ
Public thinking on animal research - Pru Hobson-West, Ashley Davies
@NottinghamVets Excellent soc sci@UoNresearch http://journals.sagepub.com/doi/abs/10.1177/0162243917736138 …ಧನ್ಯವಾದಗಳು. Twitter ಇದನ್ನು ನಿಮ್ಮ ಕಾಲರೇಖೆಯನ್ನು ಉತ್ತಮಗೊಳಿಸಲು ಬಳಸುತ್ತದೆ. ರದ್ದುಗೊಳಿಸು -
NottinghamVetSchool ಅವರು ಮರುಟ್ವೀಟಿಸಿದ್ದಾರೆ
Help
@NottinghamVets with research. Looking for vets, vet students & cattle farmers to complete this surveyhttp://bit.ly/2ha0Qtdಧನ್ಯವಾದಗಳು. Twitter ಇದನ್ನು ನಿಮ್ಮ ಕಾಲರೇಖೆಯನ್ನು ಉತ್ತಮಗೊಳಿಸಲು ಬಳಸುತ್ತದೆ. ರದ್ದುಗೊಳಿಸು -
NottinghamVetSchool ಅವರು ಮರುಟ್ವೀಟಿಸಿದ್ದಾರೆ
Interested in where you’re Animal Science degree can lead? Catch our talks tonight
@UoNBiosciences@UoNCareers@NottinghamVetspic.twitter.com/JTpwteePf2 ಧನ್ಯವಾದಗಳು. Twitter ಇದನ್ನು ನಿಮ್ಮ ಕಾಲರೇಖೆಯನ್ನು ಉತ್ತಮಗೊಳಿಸಲು ಬಳಸುತ್ತದೆ. ರದ್ದುಗೊಳಿಸು
ಧನ್ಯವಾದಗಳು. Twitter ಇದನ್ನು ನಿಮ್ಮ ಕಾಲರೇಖೆಯನ್ನು ಉತ್ತಮಗೊಳಿಸಲು ಬಳಸುತ್ತದೆ. ರದ್ದುಗೊಳಿಸು -
NottinghamVetSchool ಅವರು ಮರುಟ್ವೀಟಿಸಿದ್ದಾರೆ
Lots of great
@NottinghamVets posters at the@TheAHDB studentship seminar#AHDBStudent#GoodWorkpic.twitter.com/H82sGGmr8i ಧನ್ಯವಾದಗಳು. Twitter ಇದನ್ನು ನಿಮ್ಮ ಕಾಲರೇಖೆಯನ್ನು ಉತ್ತಮಗೊಳಿಸಲು ಬಳಸುತ್ತದೆ. ರದ್ದುಗೊಳಿಸು
ಧನ್ಯವಾದಗಳು. Twitter ಇದನ್ನು ನಿಮ್ಮ ಕಾಲರೇಖೆಯನ್ನು ಉತ್ತಮಗೊಳಿಸಲು ಬಳಸುತ್ತದೆ. ರದ್ದುಗೊಳಿಸು -
NottinghamVetSchool ಅವರು ಮರುಟ್ವೀಟಿಸಿದ್ದಾರೆ
Great to see clinically relevant findings from
@NottinghamVets year 3 research project published in the@vet_recordhttp://veterinaryrecord.bmj.com/cgi/content/full/vr.104429 …ಧನ್ಯವಾದಗಳು. Twitter ಇದನ್ನು ನಿಮ್ಮ ಕಾಲರೇಖೆಯನ್ನು ಉತ್ತಮಗೊಳಿಸಲು ಬಳಸುತ್ತದೆ. ರದ್ದುಗೊಳಿಸು -
Nottingham Vets ready for the AVS Sports weekend
#memories#Edinburghpic.twitter.com/4jZog8Its4

 ಧನ್ಯವಾದಗಳು. Twitter ಇದನ್ನು ನಿಮ್ಮ ಕಾಲರೇಖೆಯನ್ನು ಉತ್ತಮಗೊಳಿಸಲು ಬಳಸುತ್ತದೆ. ರದ್ದುಗೊಳಿಸು
ಧನ್ಯವಾದಗಳು. Twitter ಇದನ್ನು ನಿಮ್ಮ ಕಾಲರೇಖೆಯನ್ನು ಉತ್ತಮಗೊಳಿಸಲು ಬಳಸುತ್ತದೆ. ರದ್ದುಗೊಳಿಸು -
Rucksack Project Cake sale
@NottinghamVets Monday 6th November, proceeds towards filling rucksacks for the homeless community of Nottinghampic.twitter.com/FyS7DAvpeA ಧನ್ಯವಾದಗಳು. Twitter ಇದನ್ನು ನಿಮ್ಮ ಕಾಲರೇಖೆಯನ್ನು ಉತ್ತಮಗೊಳಿಸಲು ಬಳಸುತ್ತದೆ. ರದ್ದುಗೊಳಿಸು
ಧನ್ಯವಾದಗಳು. Twitter ಇದನ್ನು ನಿಮ್ಮ ಕಾಲರೇಖೆಯನ್ನು ಉತ್ತಮಗೊಳಿಸಲು ಬಳಸುತ್ತದೆ. ರದ್ದುಗೊಳಿಸು -
NottinghamVetSchool ಅವರು ಮರುಟ್ವೀಟಿಸಿದ್ದಾರೆ
It’s time to discover our
#postgraduate courses https://goo.gl/upRTYF pic.twitter.com/AokmfFEtdz ಧನ್ಯವಾದಗಳು. Twitter ಇದನ್ನು ನಿಮ್ಮ ಕಾಲರೇಖೆಯನ್ನು ಉತ್ತಮಗೊಳಿಸಲು ಬಳಸುತ್ತದೆ. ರದ್ದುಗೊಳಿಸು
ಧನ್ಯವಾದಗಳು. Twitter ಇದನ್ನು ನಿಮ್ಮ ಕಾಲರೇಖೆಯನ್ನು ಉತ್ತಮಗೊಳಿಸಲು ಬಳಸುತ್ತದೆ. ರದ್ದುಗೊಳಿಸು -
NottinghamVetSchool ಅವರು ಮರುಟ್ವೀಟಿಸಿದ್ದಾರೆ
Disease early warning system by
@NottinghamVets to deliver big benefits to#farming industry, says@vettimesukhttp://ow.ly/4l1730ggRwPಧನ್ಯವಾದಗಳು. Twitter ಇದನ್ನು ನಿಮ್ಮ ಕಾಲರೇಖೆಯನ್ನು ಉತ್ತಮಗೊಳಿಸಲು ಬಳಸುತ್ತದೆ. ರದ್ದುಗೊಳಿಸು -
NottinghamVetSchool ಅವರು ಮರುಟ್ವೀಟಿಸಿದ್ದಾರೆ
Drop-in tomorrow in The Barn
@SB_Guild 11-2pm with our Welfare Adviser Lisa@NottinghamVets@UoNSU@UoNStudentLifepic.twitter.com/XhcKxnPqHV ಧನ್ಯವಾದಗಳು. Twitter ಇದನ್ನು ನಿಮ್ಮ ಕಾಲರೇಖೆಯನ್ನು ಉತ್ತಮಗೊಳಿಸಲು ಬಳಸುತ್ತದೆ. ರದ್ದುಗೊಳಿಸು
ಧನ್ಯವಾದಗಳು. Twitter ಇದನ್ನು ನಿಮ್ಮ ಕಾಲರೇಖೆಯನ್ನು ಉತ್ತಮಗೊಳಿಸಲು ಬಳಸುತ್ತದೆ. ರದ್ದುಗೊಳಿಸು -
NottinghamVetSchool ಅವರು ಮರುಟ್ವೀಟಿಸಿದ್ದಾರೆ
Calling all students! Ingenuity18 is now open. Get involved and find your lightbulb moment! http://www.nottingham.ac.uk/go/ingenuity18
#Ingenuity18pic.twitter.com/oXTD7aAQ1c ಧನ್ಯವಾದಗಳು. Twitter ಇದನ್ನು ನಿಮ್ಮ ಕಾಲರೇಖೆಯನ್ನು ಉತ್ತಮಗೊಳಿಸಲು ಬಳಸುತ್ತದೆ. ರದ್ದುಗೊಳಿಸು
ಧನ್ಯವಾದಗಳು. Twitter ಇದನ್ನು ನಿಮ್ಮ ಕಾಲರೇಖೆಯನ್ನು ಉತ್ತಮಗೊಳಿಸಲು ಬಳಸುತ್ತದೆ. ರದ್ದುಗೊಳಿಸು -
NottinghamVetSchool ಅವರು ಮರುಟ್ವೀಟಿಸಿದ್ದಾರೆ
Are you considering a PhD after your
@UoNBiosciences or@NottinghamVets degree? This event is for you http://ow.ly/WPgR30g3TFP pic.twitter.com/sddTFI773r ಧನ್ಯವಾದಗಳು. Twitter ಇದನ್ನು ನಿಮ್ಮ ಕಾಲರೇಖೆಯನ್ನು ಉತ್ತಮಗೊಳಿಸಲು ಬಳಸುತ್ತದೆ. ರದ್ದುಗೊಳಿಸು
ಧನ್ಯವಾದಗಳು. Twitter ಇದನ್ನು ನಿಮ್ಮ ಕಾಲರೇಖೆಯನ್ನು ಉತ್ತಮಗೊಳಿಸಲು ಬಳಸುತ್ತದೆ. ರದ್ದುಗೊಳಿಸು -
NottinghamVetSchool ಅವರು ಮರುಟ್ವೀಟಿಸಿದ್ದಾರೆ
For any
@UoNBiosciences and@NottinghamVets looking to get involved and#gettheAdvantagehttps://twitter.com/AdvantageAward/status/925271304034488320 … ಧನ್ಯವಾದಗಳು. Twitter ಇದನ್ನು ನಿಮ್ಮ ಕಾಲರೇಖೆಯನ್ನು ಉತ್ತಮಗೊಳಿಸಲು ಬಳಸುತ್ತದೆ. ರದ್ದುಗೊಳಿಸು
ಧನ್ಯವಾದಗಳು. Twitter ಇದನ್ನು ನಿಮ್ಮ ಕಾಲರೇಖೆಯನ್ನು ಉತ್ತಮಗೊಳಿಸಲು ಬಳಸುತ್ತದೆ. ರದ್ದುಗೊಳಿಸು -
NottinghamVetSchool ಅವರು ಮರುಟ್ವೀಟಿಸಿದ್ದಾರೆ
Early warning health and welfare system could save
#farmers millions and reduce#antibiotic use http://ow.ly/cXZu30gfd6l@NottinghamVetsಧನ್ಯವಾದಗಳು. Twitter ಇದನ್ನು ನಿಮ್ಮ ಕಾಲರೇಖೆಯನ್ನು ಉತ್ತಮಗೊಳಿಸಲು ಬಳಸುತ್ತದೆ. ರದ್ದುಗೊಳಿಸು -
Don't miss the
@SBFarmersMkt this week. Come along to the Sutton Bonington campus on Wednesday 11 - 3
#localandfreshಧನ್ಯವಾದಗಳು. Twitter ಇದನ್ನು ನಿಮ್ಮ ಕಾಲರೇಖೆಯನ್ನು ಉತ್ತಮಗೊಳಿಸಲು ಬಳಸುತ್ತದೆ. ರದ್ದುಗೊಳಿಸು
ಲೋಡಿಂಗ್ ಸಮಯ ಸ್ವಲ್ಪ ತೆಗೆದುಕೊಳ್ಳುತ್ತಿರುವಂತೆನಿಸುತ್ತದೆ.
Twitter ಸಾಮರ್ಥ್ಯ ಮೀರಿರಬಹುದು ಅಥವಾ ಕ್ಷಣಿಕವಾದ ತೊಂದರೆಯನ್ನು ಅನುಭವಿಸುತ್ತಿರಬಹುದು. ಮತ್ತೆ ಪ್ರಯತ್ನಿಸಿ ಅಥವಾ ಹೆಚ್ಚಿನ ಮಾಹಿತಿಗೆ Twitter ಸ್ಥಿತಿಗೆ ಭೇಟಿ ನೀಡಿ.















